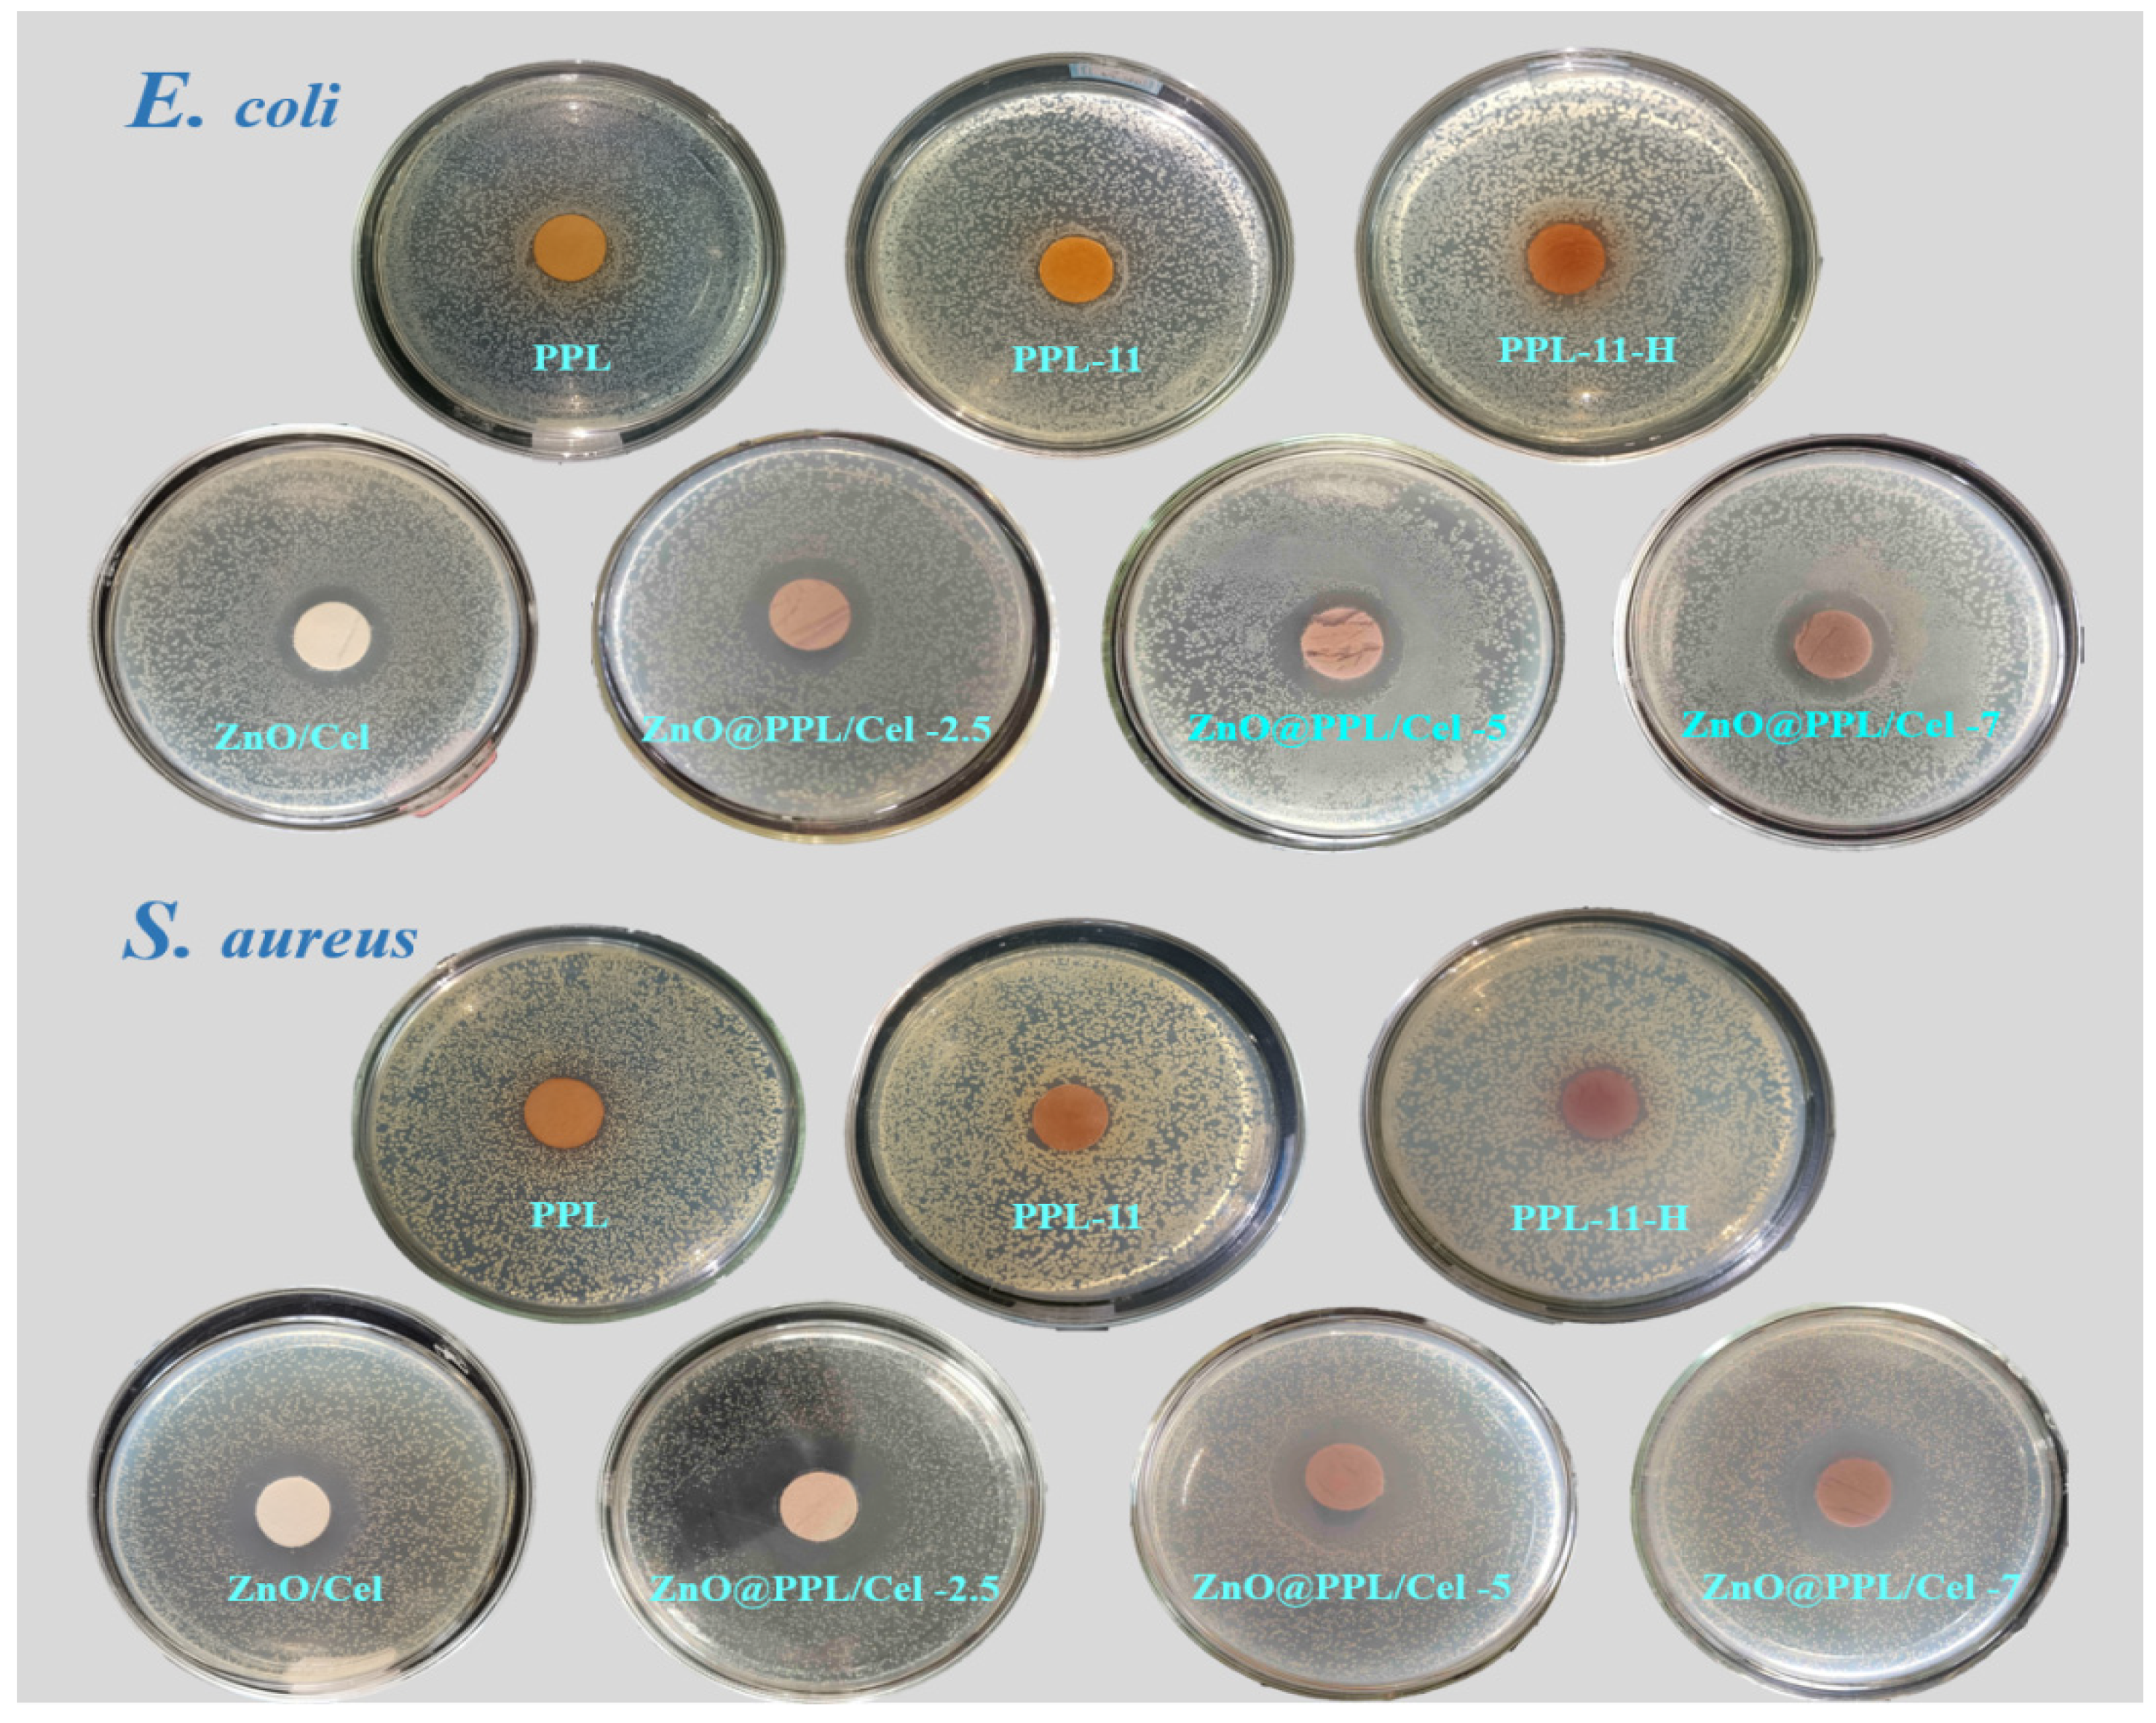
Ijms 23 05218 g008 550

Fabrication of ZnO@Plant Polyphenols/Cellulose as Active Food Packaging and Its Enhanced Antibacterial Activity
Abstract
:1. Introduction
2. Materials and Methods
2.1. Reagents
2.2. Extraction of PPL
2.3. Preparation of ZnO@PPL/Cel
2.4. Antioxidant Experiments
2.5. Antibacterial Experiments
2.6. Water Vapor Transmission Rate (WVTR) Experiments
2.7. Characterization
3. Results and Discussion
3.1. Structure of ZnO@PPL/Cel
3.2. Morphology Study
3.3. XPS and Raman Analysis
3.4. Solid UV Diffuse Reflection and PL Spectra
3.5. Antioxidant, Antibacterial Activity and Water Vapor Transmission Property
4. Conclusions
Author Contributions
Funding
Institutional Review Board Statement
Data Availability Statement
Acknowledgments
Conflicts of Interest
References
- Guzel Kaya, G.; Aznar, E.; Deveci, H.; Martinez-Manez, R. Aerogels as promising materials for antibacterial applications: A mini-review. Biomater. Sci. 2021, 9, 7034–7048. [Google Scholar] [CrossRef] [PubMed]
- Olmos, D.; Gonzalez-Benito, J. Polymeric Materials with Antibacterial Activity: A Review. Polymers 2021, 13, 613. [Google Scholar] [CrossRef] [PubMed]
- Sun, Y.; Yin, W.-M.; Wang, Y.; Zhao, N.-D.; Wang, X.-Y.; Zhang, J.-G.; Guo, Y.-R.; Li, S.; Pan, Q.-J. Fabrication of ultra-thin MgAl layered double oxide by cellulose templating and its immobilization effect toward heavy metal ions: Cation-exchange and deposition mechanism. Chem. Eng. J. 2022, 427, 132017. [Google Scholar] [CrossRef]
- Zhao, N.-D.; Wang, Y.; Zou, X.-H.; Yin, W.-M.; Wang, X.-Y.; Guo, Y.-R.; Pan, Q.-J. Fabrication of cellulose@Mg(OH)2 composite filter via interfacial bonding and its trapping effect for heavy metal ions. Chem. Eng. J. 2021, 426, 130812. [Google Scholar] [CrossRef]
- Bian, Y.; Wei, J.; Zhao, C.; Li, G. Natural Polyphenols Targeting Senescence: A Novel Prevention and Therapy Strategy for Cancer. Int. J. Mol. Sci. 2020, 21, 684. [Google Scholar] [CrossRef] [PubMed] [Green Version]
- Costea, T.; Nagy, P.; Ganea, C.; Szollosi, J.; Mocanu, M.-M. Molecular Mechanisms and Bioavailability of Polyphenols in Prostate Cancer. Int. J. Mol. Sci. 2019, 20, 1062. [Google Scholar] [CrossRef] [PubMed] [Green Version]
- Luo, Y.; Jian, Y.; Liu, Y.; Jiang, S.; Muhammad, D.; Wang, W. Flavanols from Nature: A Phytochemistry and Biological Activity Review. Molecules 2022, 27, 719. [Google Scholar] [CrossRef] [PubMed]
- Minnelli, C.; Cianfruglia, L.; Laudadio, E.; Mobbili, G.; Galeazzi, R.; Armeni, T. Effect of Epigallocatechin-3-Gallate on EGFR Signaling and Migration in Non-Small Cell Lung Cancer. Int. J. Mol. Sci. 2021, 22, 11833. [Google Scholar] [CrossRef]
- Kadri, S.; El Ayed, M.; Mabrouk, M.; Limam, F.; Elkahoui, S.; Aouani, E.; Mokni, M. Characterization, anti-oxidative effect of grape seed powder and in silico affinity profiling of polyphenolic and extra-phenolic compounds for calpain inhibition. J. Pharm. Biomed. Anal. 2019, 164, 365–372. [Google Scholar] [CrossRef]
- Marchelak, A.; Olszewska, M.A.; Owczarek, A. Simultaneous quantification of thirty polyphenols in blackthorn flowers and dry extracts prepared thereof: HPLC-PDA method development and validation for quality control. J. Pharm. Biomed. Anal. 2020, 184, 113121. [Google Scholar] [CrossRef]
- Pacifico, S.; Piccolella, S.; Nocera, P.; Tranquillo, E.; Dal Poggetto, F.; Catauro, M. New insights into phenol and polyphenol composition of Stevia rebaudiana leaves. J. Pharm. Biomed. Anal. 2019, 163, 45–57. [Google Scholar] [CrossRef] [PubMed]
- Tang, H.; Cao, Y.; Liu, L.; Zhang, Y.; Li, W.; Tu, P.; Li, J.; Song, Y. High-level structural analysis of proanthocyanidins using full collision energy ramp-MS2 spectrum. J. Pharm. Biomed. Anal. 2022, 211, 114634. [Google Scholar] [CrossRef]
- Contessa, C.R.; da Rosa, G.S.; Moraes, C.C. New Active Packaging Based on Biopolymeric Mixture Added with Bacteriocin as Active Compound. Int. J. Mol. Sci. 2021, 22, 10628. [Google Scholar] [CrossRef] [PubMed]
- Lai, W.-F. Design of Polymeric Films for Antioxidant Active Food Packaging. Int. J. Mol. Sci. 2022, 23, 12. [Google Scholar] [CrossRef]
- Ordon, M.; Zdanowicz, M.; Nawrotek, P.; Stachurska, X.; Mizielinska, M. Polyethylene Films Containing Plant Extracts in the Polymer Matrix as Antibacterial and Antiviral Materials. Int. J. Mol. Sci. 2021, 22, 13438. [Google Scholar] [CrossRef]
- Thi Minh Phuong, N.; Thanh Hoi, N.; Thi Mong Quyen, D.; Thi Xo, T.; Rachtanapun, P. Characteristics and Antimicrobial Properties of Active Edible Films Based on Pectin and Nanochitosan. Int. J. Mol. Sci. 2020, 21, 2224. [Google Scholar] [CrossRef] [Green Version]
- Zhang, K.; Gao, C.; Song, J.; Song, C.; Wang, Z.; Wu, Y.; Liu, Y.; Sun, J. A type of dissoluble organosilicon elastomer with stretchable, self-healable and antibacterial properties. Polym. Test. 2021, 96, 107082. [Google Scholar] [CrossRef]
- Yu, Y.; Yang, Z.; Ren, S.; Gao, Y.; Zheng, L. Multifunctional hydrogel based on ionic liquid with antibacterial performance. J. Mol. Liq. 2020, 299, 112185. [Google Scholar] [CrossRef]
- Xin, Q.; Shah, H.; Nawaz, A.; Xie, W.; Akram, M.Z.; Batool, A.; Tian, L.; Jan, S.U.; Boddula, R.; Guo, B.; et al. Antibacterial Carbon-Based Nanomaterials. Adv. Mater. 2019, 31, 1804838. [Google Scholar] [CrossRef]
- Wen, Y.; Yu, B.; Zhu, Z.; Yang, Z.; Shao, W. Synthesis of Antibacterial Gelatin/Sodium Alginate Sponges and Their Antibacterial Activity. Polymers 2020, 12, 1926. [Google Scholar] [CrossRef]
- Tavakolian, M.; Jafari, S.M.; van de Ven, T.G.M. A Review on Surface-Functionalized Cellulosic Nanostructures as Biocompatible Antibacterial Materials. Nano-Micro Lett. 2020, 12, 73–95. [Google Scholar] [CrossRef] [PubMed] [Green Version]
- Du, J.; Li, Y.; Wang, J.; Wang, C.; Liu, D.; Wang, G.; Liu, S. Mechanically Robust, Self-Healing, Polymer Blends and Polymer/Small Molecule Blend Materials with High Antibacterial Activity. ACS Appl. Mater. Interfaces 2020, 12, 26966–26972. [Google Scholar] [CrossRef] [PubMed]
- Maghsoudi, S.; Nasiri Pour, P.; Ebrahimnejad, H.; Jalali, E.; Zangiabadi, M. Decoration of Cotton Fiber with Biosynthesized Ag/ZnO Nanocomposite for Durable Antibacterial Textile. J. Nat. Fibers 2021. [Google Scholar] [CrossRef]
- Shen, M.; Forghani, F.; Kong, X.; Liu, D.; Ye, X.; Chen, S.; Ding, T. Antibacterial applications of metal-organic frameworks and their composites. Compr. Rev. Food Sci. Food Saf. 2020, 19, 1397–1419. [Google Scholar] [CrossRef] [Green Version]
- Hui, A.; Yan, R.; Wang, W.; Wang, Q.; Zhou, Y.; Wang, A. Incorporation of quaternary ammonium chitooligosaccharides on ZnO/palygorskite nanocomposites for enhancing antibacterial activities. Carbohydr. Polym. 2020, 247, 116685. [Google Scholar] [CrossRef]
- Teymourinia, H.; Amiri, O.; Salavati-Niasari, M. Synthesis and characterization of cotton-silver-graphene quantum dots (cotton/Ag/GQDs) nanocomposite as a new antibacterial nanopad. Chemosphere 2021, 267, 129293. [Google Scholar] [CrossRef]
- Fu, S.; Zhang, Y.; Qin, G.; Zhang, E. Antibacterial effect of Ti-Ag alloy motivated by Ag-containing phases. Mater. Sci. Eng. C-Mater. Biol. Appl. 2021, 128, 112266. [Google Scholar] [CrossRef]
- Zheng, K.; Balasubramanian, P.; Paterson, T.E.; Stein, R.; MacNei, S.; Fiorilli, S.; Vitale-Brovarone, C.; Shepherd, J.; Boccaccini, A.R. Ag modified mesoporous bioactive glass nanoparticles for enhanced antibacterial activity in 3D infected skin model. Mater. Sci. Eng. C-Mater. Biol. Appl. 2019, 103, 109764. [Google Scholar] [CrossRef]
- Xie, Y.; Yue, L.; Zheng, Y.; Zhao, L.; Liang, C.; He, W.; Liu, Z.; Sun, Y.; Yang, Y. The antibacterial stability of poly(dopamine) in-situ reduction and chelation nano-Ag based on bacterial cellulose network template. Appl. Surf. Sci. 2019, 491, 383–394. [Google Scholar] [CrossRef]
- Wang, Z.; Fang, Y.; Zhou, X.; Li, Z.; Zhu, H.; Du, F.; Yuan, X.; Yao, Q.; Xie, J. Embedding ultrasmall Ag nanoclusters in Luria-Bertani extract via light irradiation for enhanced antibacterial activity. Nano Res. 2020, 13, 203–208. [Google Scholar] [CrossRef]
- Liu, J.; Wang, Y.; Ma, J.; Peng, Y.; Wang, A. A review on bidirectional analogies between the photocatalysis and antibacterial properties of ZnO. J. Alloys Compd. 2019, 783, 898–918. [Google Scholar] [CrossRef]
- Jin, Y.; Long, J.; Ma, X.; Zhou, T.; Zhang, Z.; Lin, H.; Long, J.; Wang, X. Synthesis of caged iodine-modified ZnO nanomaterials and study on their visible light photocatalytic antibacterial properties. Appl. Catal. B-Environ. 2019, 256, 117873. [Google Scholar] [CrossRef]
- Jan, T.; Azmat, S.; Wahid, B.; Adil, M.; Alawadhi, H.; Mansoor, Q.; Farooq, Z.; Ilyas, S.Z.; Ahmad, I.; Ismail, M. Chemically synthesized ZnO-Bi2O3 (BZO) nanocomposites with tunable optical, photoluminescence and antibacterial characteristics. Mater. Sci. Semicond. Process. 2018, 84, 71–75. [Google Scholar] [CrossRef]
- Selvinsimpson, S.; Gnanamozhi, P.; Pandiyan, V.; Govindasamy, M.; Habila, M.A.; AlMasoud, N.; Chen, Y. Synergetic effect of Sn doped ZnO nanoparticles synthesized via ultrasonication technique and its photocatalytic and antibacterial activity. Environ. Res. 2021, 197, 111115. [Google Scholar] [CrossRef] [PubMed]
- Li, D.; Wu, W.; Zhao, Y.; Qiao, R. Type-II heterojunction constructed by Ag2S-coupled ZnO microspheres with visible light-responsive antibacterial activity. Mater. Lett. 2020, 271, 127709. [Google Scholar] [CrossRef]
- Zou, X.-H.; Zhao, S.-W.; Zhang, J.-G.; Sun, H.-L.; Pan, Q.-J.; Guo, Y.-R. Preparation of ternary ZnO/Ag/cellulose and its enhanced photocatalytic degradation property on phenol and benzene in VOCs. Open Chem. 2019, 17, 779–787. [Google Scholar] [CrossRef]
- Jablonska, J.; Onyszko, M.; Konopacki, M.; Augustyniak, A.; Rakoczy, R.; Mijowska, E. Fabrication of Paper Sheets Coatings Based on Chitosan/Bacterial Nanocellulose/ZnO with Enhanced Antibacterial and Mechanical Properties. Int. J. Mol. Sci. 2021, 22, 7383. [Google Scholar] [CrossRef]
- Supramaniam, J.; Low, D.Y.S.; Wong, S.K.; Tan, L.T.H.; Leo, B.F.; Goh, B.H.; Darji, D.; Mohd Rasdi, F.R.; Chan, K.G.; Lee, L.H.; et al. Facile Synthesis and Characterization of Palm CNF-ZnO Nanocomposites with Antibacterial and Reinforcing Properties. Int. J. Mol. Sci. 2021, 22, 5781. [Google Scholar] [CrossRef]
- Zhao, S.-W.; Guo, C.-R.; Hu, Y.-Z.; Guo, Y.-R.; Pan, Q.-J. The preparation and antibacterial activity of cellulose/ZnO composite: A review. Open Chem. 2018, 16, 9–20. [Google Scholar] [CrossRef]
- Gamba Miglioranza, B.M.; Spinelli, F.R.; Stoffel, F.; Piemolini-Barreto, L.T. Biodegradable film for raisins packaging application: Evaluation of physico-chemical characteristics and antioxidant potential. Food Chem. 2021, 365, 130538. [Google Scholar] [CrossRef]
- Fei, P.; Xu, Y.; Zhao, S.; Gong, S.; Guo, L. Olive oil polyphenol extract inhibits vegetative cells of Bacillus cereus isolated from raw milk. J. Dairy Sci. 2019, 102, 3894–3902. [Google Scholar] [CrossRef] [PubMed]
- Kazempour-Samak, M.; Rashidi, L.; Ghavami, M.; Sharifan, A.; Hosseini, F. Antibacterial and antioxidant activity of sour cherry kernel oil (Cerasus vulgaris Miller) against some food-borne microorganisms. J. Food Meas. Charact. 2021, 15, 4686–4695. [Google Scholar] [CrossRef]
- Tedeschi, A.M.; Di Caprio, F.; Piozzi, A.; Pagnanelli, F.; Francolini, I. Sustainable Bioactive Packaging Based on Thermoplastic Starch and Microalgae. Int. J. Mol. Sci. 2022, 23, 178. [Google Scholar] [CrossRef] [PubMed]
- Zhao, S.-W.; Zuo, H.-F.; Guo, Y.-R.; Pan, Q.-J. Carbon-doped ZnO aided by carboxymethyl cellulose: Fabrication, photoluminescence and photocatalytic applications. J. Alloys Compd. 2017, 695, 1029–1037. [Google Scholar] [CrossRef]
- Foo, L.Y. Proanthocyanidins: Gross chemical structures by infrared spectra. Phytochemistry 1981, 20, 1397–1402. [Google Scholar] [CrossRef]
- Chen, S.; Song, J.; Du, L.; Ma, Y.; Ren, S.; Ren, J.; Li, S. Quantitative Analysis of Solubility Parameters and Surface Properties of Larch Bark Proanthocyanidins. Polymers 2020, 12, 2800. [Google Scholar] [CrossRef]
- Fiore, A.; Park, S.; Volpe, S.; Torrieri, E.; Masi, P. Active packaging based on PLA and chitosan-caseinate enriched rosemary essential oil coating for fresh minced chicken breast application. Food Packag. Shelf Life 2021, 29, 100708. [Google Scholar] [CrossRef]
- Gupta, R.; Malik, P.; Das, N.; Singh, M. Antioxidant and physicochemical study of Psidium guajava prepared zinc oxide nanoparticles. J. Mol. Liq. 2019, 275, 749–767. [Google Scholar] [CrossRef]
- Zhao, S.-W.; Zheng, M.; Sun, H.-L.; Li, S.-J.; Pan, Q.-J.; Guo, Y.-R. Construction of heterostructured g-C3N4/ZnO/cellulose and its antibacterial activity: Experimental and theoretical investigations. Dalton Trans. 2020, 49, 3723–3734. [Google Scholar] [CrossRef]
- Zhao, S.-W.; Zheng, M.; Zou, X.-H.; Guo, Y.; Pan, Q.-J. Self-Assembly of Hierarchically Structured Cellulose@ZnO Composite in Solid-Liquid Homogeneous Phase: Synthesis, DFT Calculations, and Enhanced Antibacterial Activities. ACS Sustain. Chem. Eng. 2017, 5, 6585–6596. [Google Scholar] [CrossRef]
- Cushnie, T.P.T.; Lamb, A.J. Antimicrobial activity of flavonoids. Int. J. Antimicrob. Agents 2005, 26, 343–356. [Google Scholar] [CrossRef] [PubMed]
- Daglia, M. Polyphenols as antimicrobial agents. Curr. Opin. Biotechnol. 2012, 23, 174–181. [Google Scholar] [CrossRef] [PubMed]

| Samples | Diameter of Sample (mm) | Diameter of Inhibition Zone (mm) | Width of Inhibition Zone (mm) | ||
|---|---|---|---|---|---|
| E. coli | S. aureus | E. coli | S. aureus | ||
| ZnO/Cel | 15.0 | 22.6 ± 0.23 | 26.8 ± 0.32 | 3.8 ± 0.11 | 5.9 ± 0.16 |
| ZnO@PPL/Cel-2.5 | 15.0 | 24.8 ± 0.42 | 31.0 ± 0.30 | 4.9 ± 0.21 | 8.0 ± 0.15 |
| ZnO@PPL/Cel-5 | 15.0 | 25.0 ± 0.06 | 31.2 ± 0.28 | 5.0 ± 0.03 | 8.1 ± 0.14 |
| ZnO@PPL/Cel-7 | 15.0 | 25.2 ± 0.04 | 31.4 ± 0.42 | 5.1 ± 0.02 | 8.2 ± 0.21 |
Publisher’s Note: MDPI stays neutral with regard to jurisdictional claims in published maps and institutional affiliations. |
© 2022 by the authors. Licensee MDPI, Basel, Switzerland. This article is an open access article distributed under the terms and conditions of the Creative Commons Attribution (CC BY) license (https://creativecommons.org/licenses/by/4.0/).
Share and Cite
Nie, J.; Wu, Z.; Pang, B.; Guo, Y.; Li, S.; Pan, Q. Fabrication of ZnO@Plant Polyphenols/Cellulose as Active Food Packaging and Its Enhanced Antibacterial Activity. Int. J. Mol. Sci. 2022, 23, 5218. https://doi.org/10.3390/ijms23095218
Nie J, Wu Z, Pang B, Guo Y, Li S, Pan Q. Fabrication of ZnO@Plant Polyphenols/Cellulose as Active Food Packaging and Its Enhanced Antibacterial Activity. International Journal of Molecular Sciences. 2022; 23(9):5218. https://doi.org/10.3390/ijms23095218
Chicago/Turabian StyleNie, Jingheng, Ziyang Wu, Bo Pang, Yuanru Guo, Shujun Li, and Qingjiang Pan. 2022. "Fabrication of ZnO@Plant Polyphenols/Cellulose as Active Food Packaging and Its Enhanced Antibacterial Activity" International Journal of Molecular Sciences 23, no. 9: 5218. https://doi.org/10.3390/ijms23095218
APA StyleNie, J., Wu, Z., Pang, B., Guo, Y., Li, S., & Pan, Q. (2022). Fabrication of ZnO@Plant Polyphenols/Cellulose as Active Food Packaging and Its Enhanced Antibacterial Activity. International Journal of Molecular Sciences, 23(9), 5218. https://doi.org/10.3390/ijms23095218

